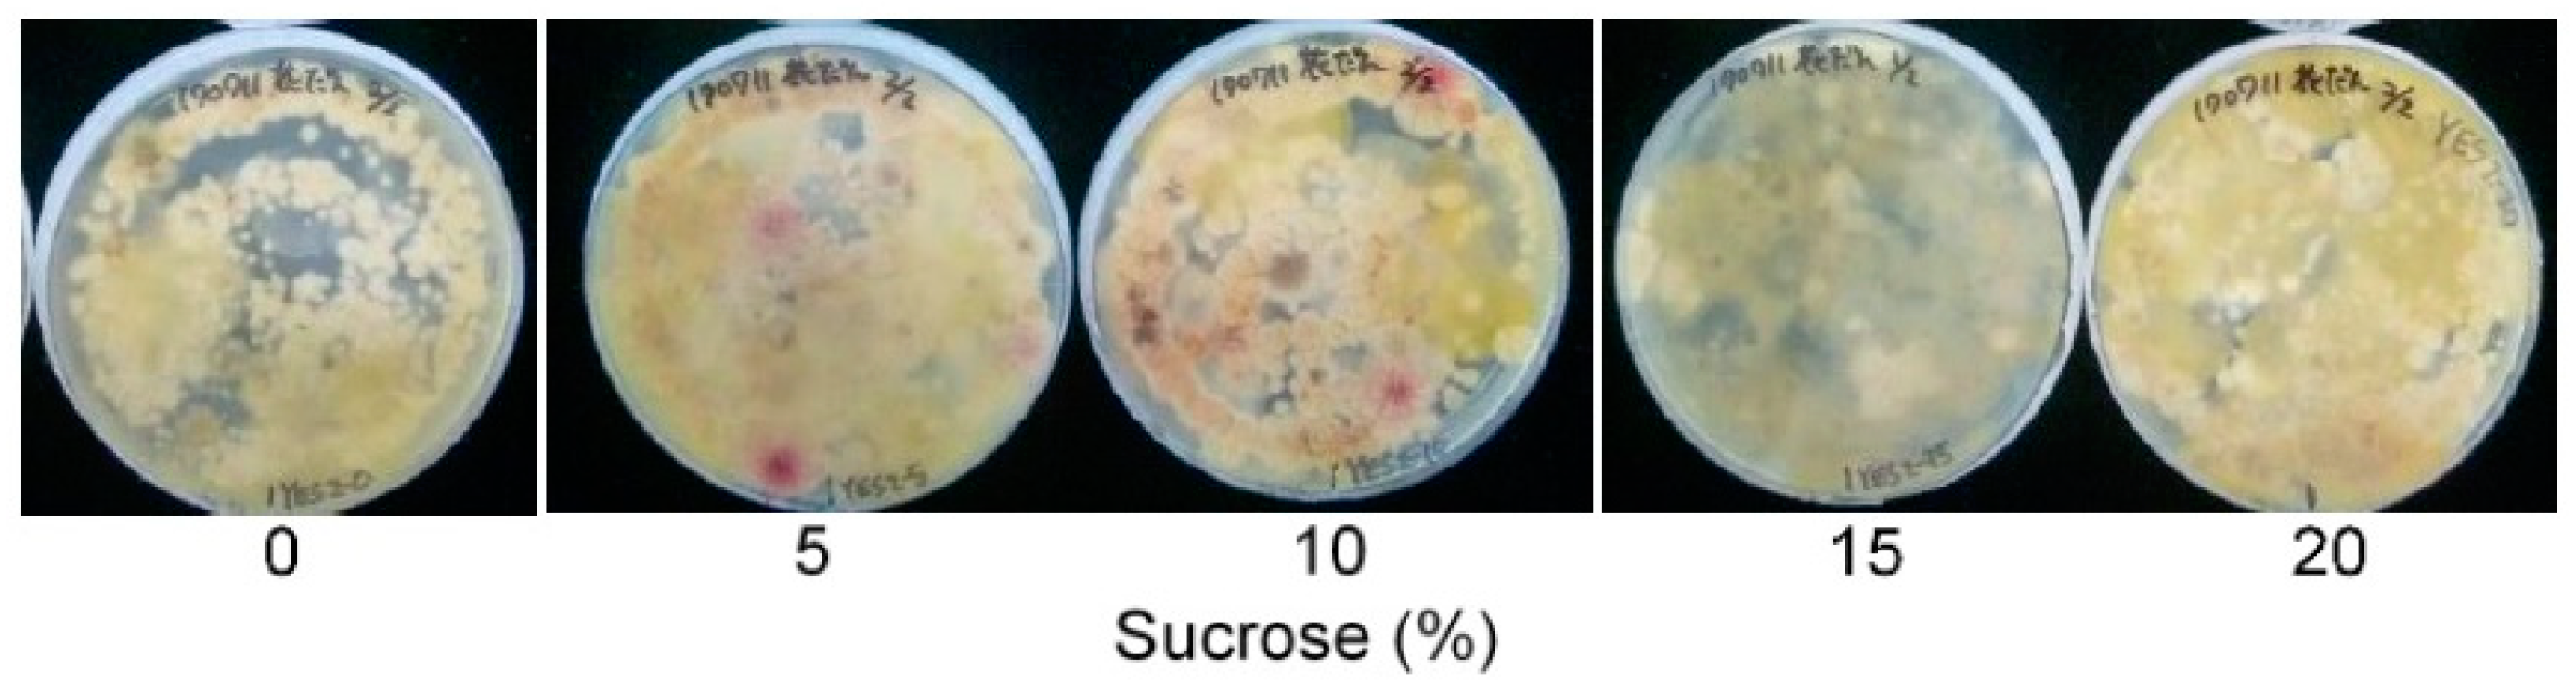
Toxins 10 00519 g003
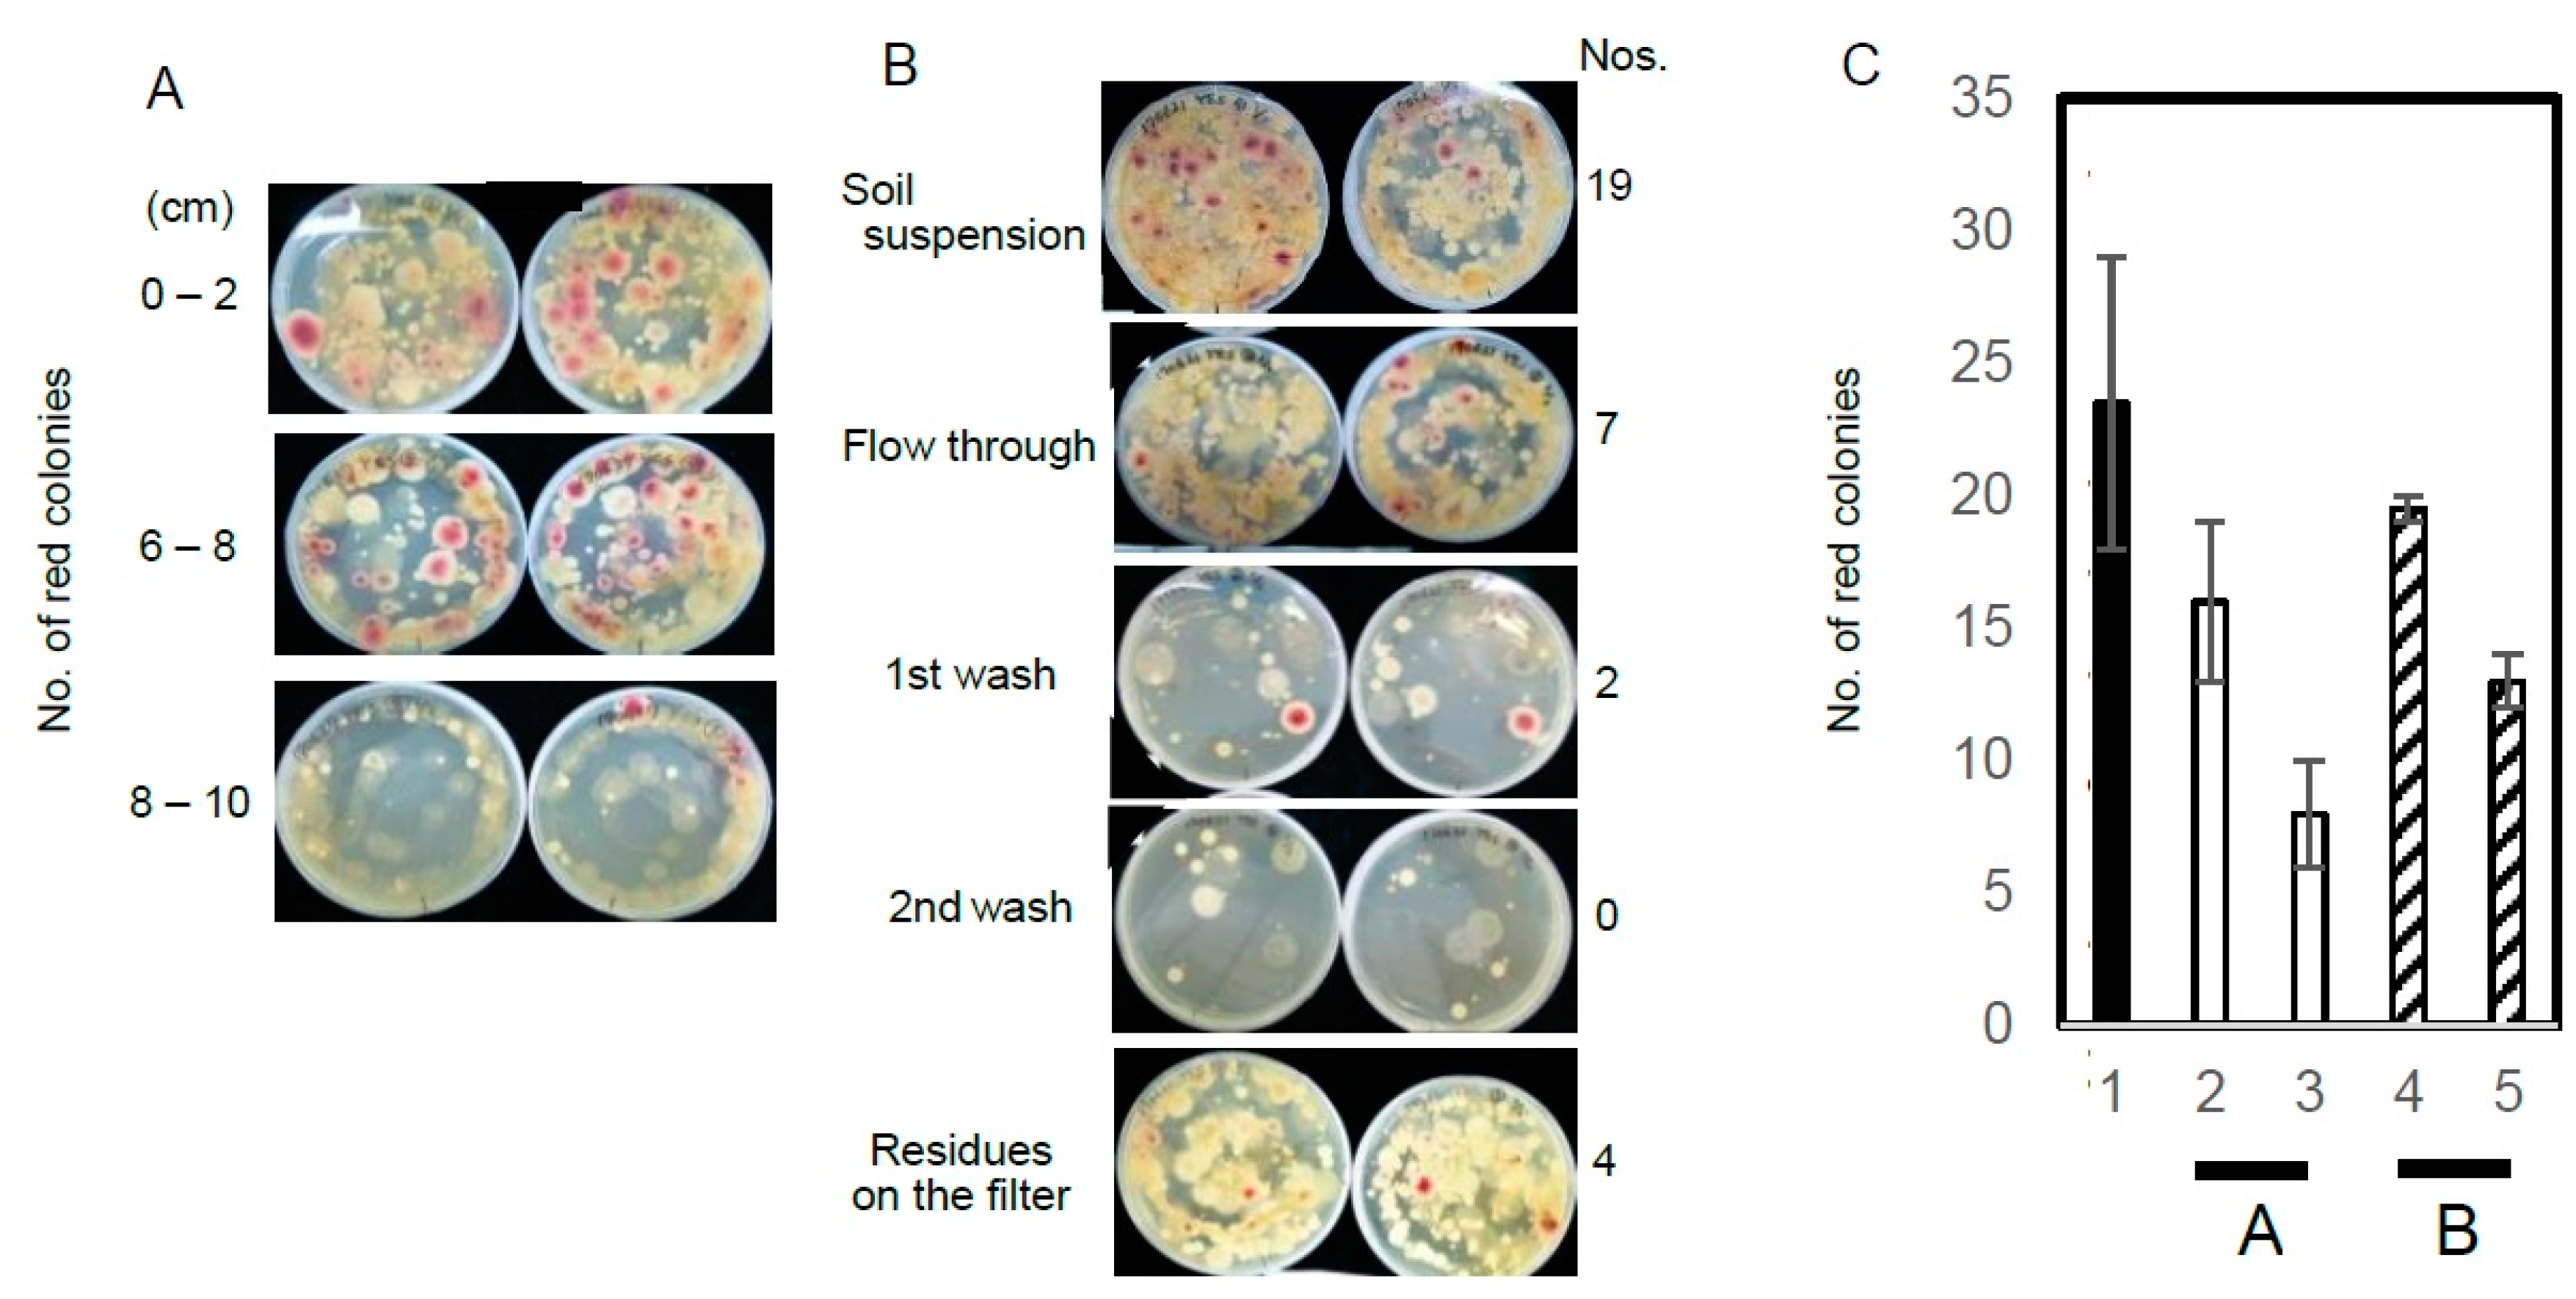
Toxins 10 00519 g005
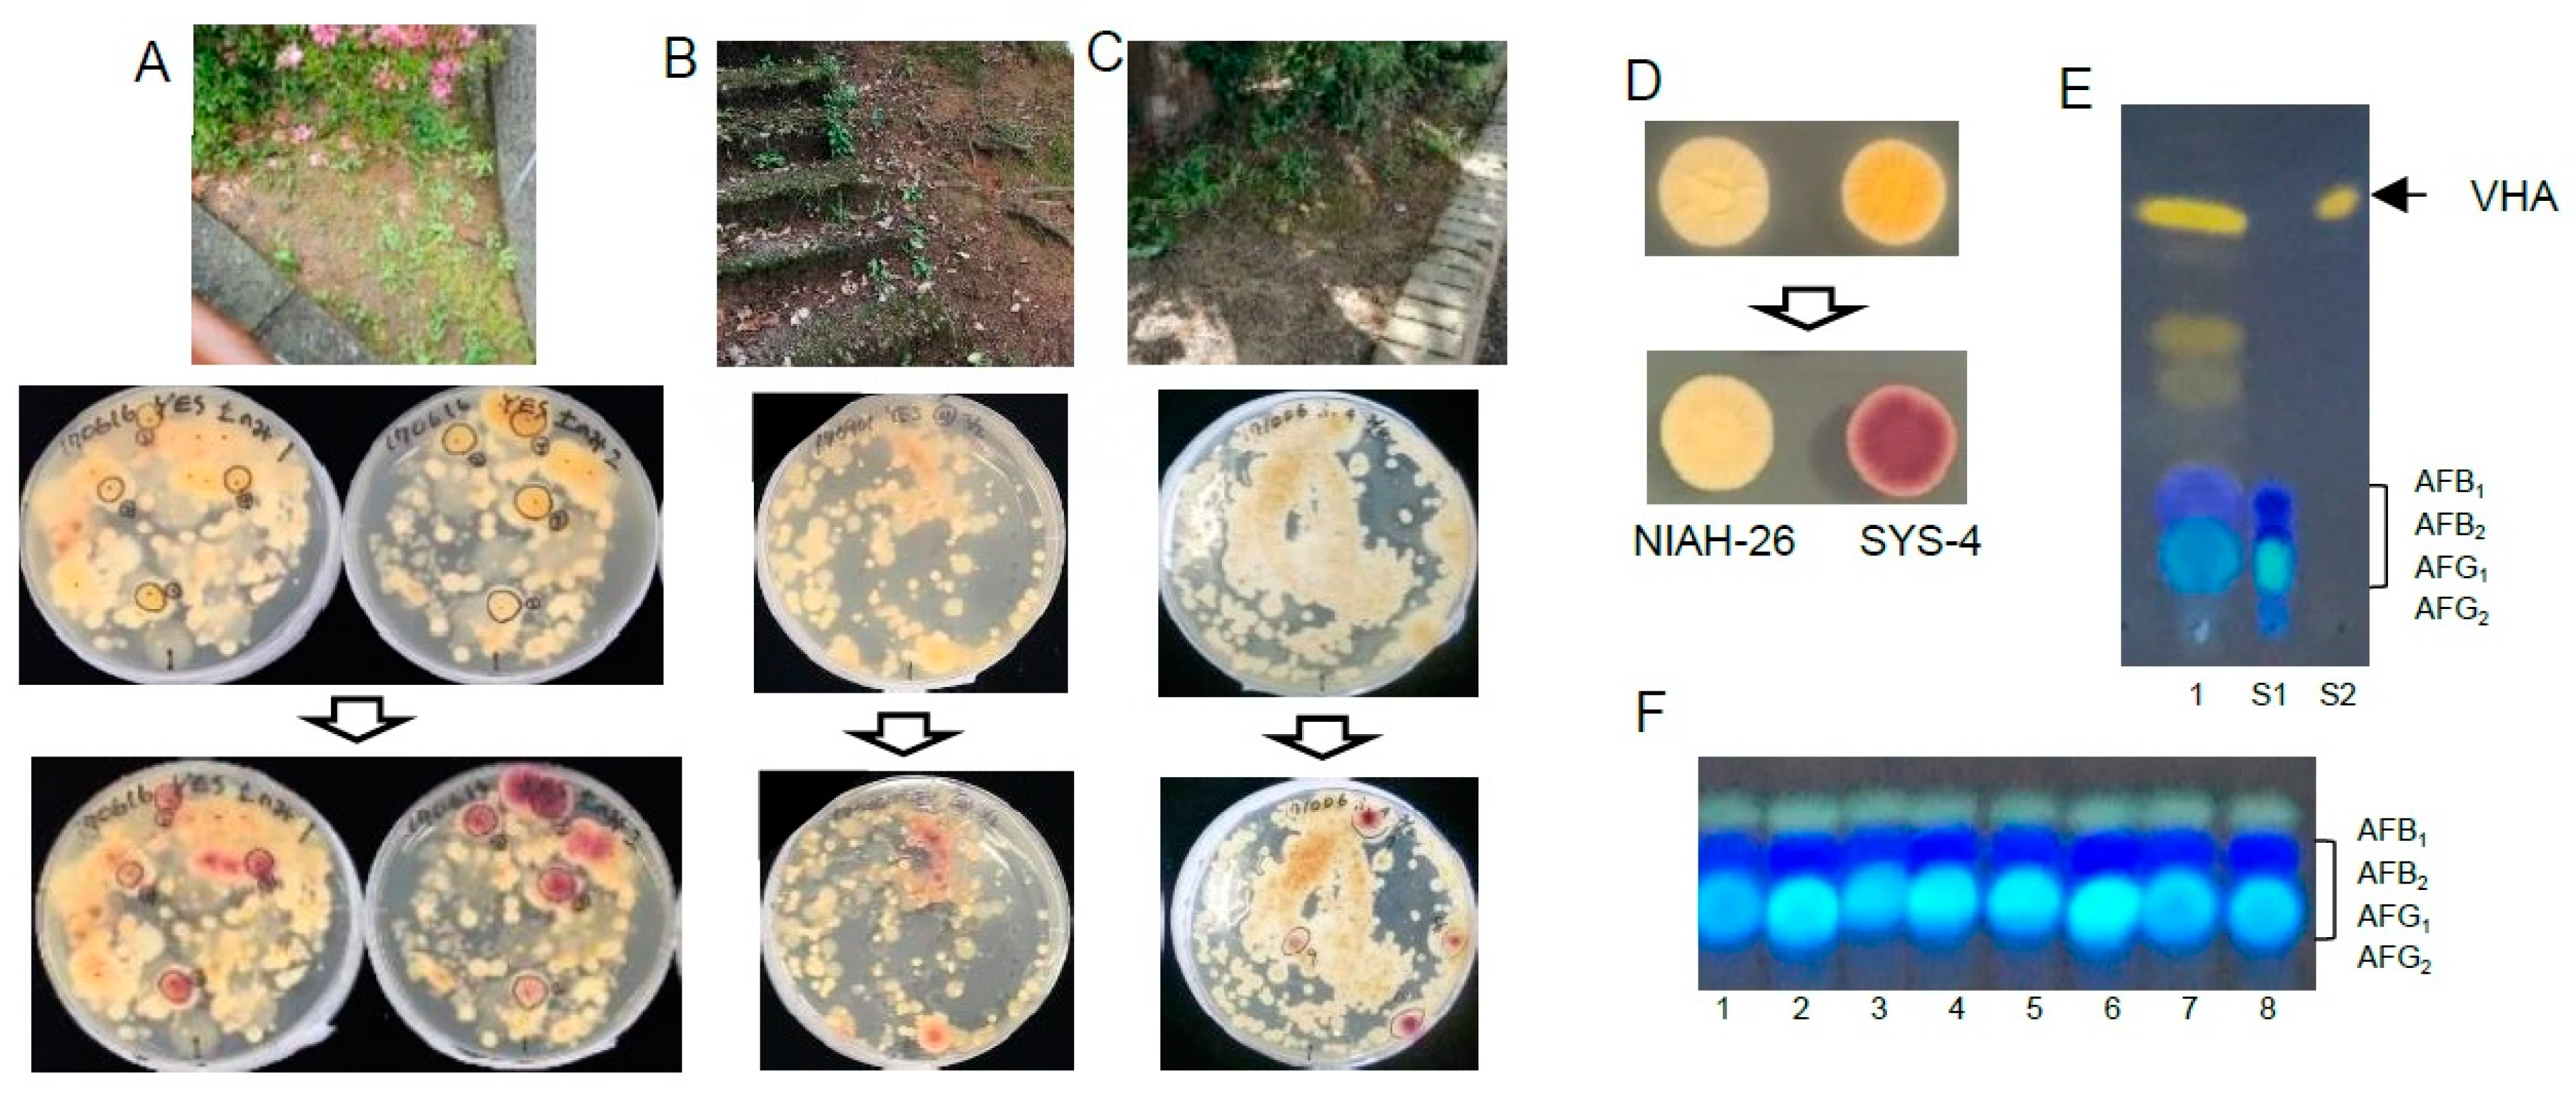
Toxins 10 00519 g006

Improvement of the Culture Medium for the Dichlorvos-Ammonia (DV-AM) Method to Selectively Detect Aflatoxigenic Fungi in Soil
Abstract
1. Introduction
2. Results
2.1. The Effect of the Carbon Source on the DV-AM Method’s Results
2.2. The Effect of Detergents in the Media
2.3. The Characterization of Aflatoxigenic Fungi in Soils and the Recovery of the Aflatoxigenic Fungi from Soils
2.4. Application of the Improved Medium for the DV-AM Method
3. Discussion
3.1. The Selection Medium for Aflatoxigenic Fungi
3.2. Application of the Selection Medium with the DV-AM Method for Aflatoxigenic Fungi in Non-Agricultural Fields in Fukui City
4. Conclusions
5. Materials and Methods
5.1. Microorganisms
5.2. Media
5.3. DV-AM Method
5.4. Collection and Storage of Soils
5.5. The Morphology of the Aflatoxigenic Fungi in FUT Soil
5.6. Recovery of Aflatoxigenic Fungi from Soils by the DV-AM Method
5.7. Characterization of the Isolated Fungi
5.8. Identification of the Fungi
Author Contributions
Funding
Acknowledgments
Conflicts of Interest
References
- Kumar, P.; Mahato, D.K.; Kamle, M.; Mohanta, T.K.; Kang, S.G. Aflatoxins: A global concern for food safety, human health and their management. Front. Microbiol. 2017, 7, 1–10. [Google Scholar] [CrossRef]
- Lizárraga-Paulín, E.G.; Moreno-Martínez, E.; Miranda-Castro, S.P. Aflatoxins and their Impact on Human and Animal Health: An Emerging Problem. In Aflatoxins-Biochemistry and Molecular Biology; InTech: London, UK, 2010; pp. 1–28. [Google Scholar]
- Klich, M.A. Biogeography of Aspergillus species in soil and litter. Mycologia 2002, 94, 21–27. [Google Scholar] [CrossRef] [PubMed]
- Wu, F.; Guclu, H. Aflatoxin Regulations in a Network of Global Maize Trade. PLoS ONE 2012, 7, e45151. [Google Scholar] [CrossRef] [PubMed]
- Pitt, J.I. Mycotoxins: Aflatoxins. In Encyclopedia for Food Safety; Motarjemi, Y., Gerald, M., Ewen, T., Eds.; Academic Press: Waltham, MA, USA, 2014; Volume 2, pp. 289–294. [Google Scholar]
- Horn, B.W. Ecology and Population Biology of Aflatoxigenic Fungi in Soil. Toxin Rev. 2003, 22, 351–379. [Google Scholar] [CrossRef]
- Peterson, S.W.; Ito, Y.; Horn, B.W.; Goto, T. Aspergillus bombycis, a new aflatoxigenic species and genetic variation in its sibling species, A. nomius. Mycologia 2001, 93, 689–703. [Google Scholar] [CrossRef]
- Rodrigues, P.; Soares, C.; Kozakiewicz, Z.; Paterson, R.R.M.; Lima, N. Identification and characterization of Aspergillus flavus and aflatoxins. Commun. Curr. Res. Educ. Top. Trends Appl. Microbiol. 2007, 527–534. Available online: https://bibliotecadigital.ipb.pt/bitstream/10198/933/1/Rodrigues_et_al,_2007.pdf (accessed on 12 October 2018).
- Moore, G.G.; Mack, B.M.; Beltz, S.B. Genomic sequence of the aflatoxigenic filamentous fungus Aspergillus nomius. BMC Genomics 2015, 16, 551. [Google Scholar] [CrossRef]
- Baranyi, N.; Kocsubé, S.; Szekeres, A.; Raghavan, A.; Narendran, V.; Vágvölgyi, C.; Panneer Selvam, K.; Babu Singh, Y.R.; Kredics, L.; Varga, J.; et al. Keratitis caused by Aspergillus pseudotamarii. Med. Mycol. Case Rep. 2013, 2, 91–94. [Google Scholar] [CrossRef]
- Ito, Y.; Peterson, S.W.; Wicklow, D.T.; Goto, T. Aspergillus pseudotamarii, a new aflatoxin producing species in Aspergillus section Flavi. Mycol. Res. 2001, 105, 233–239. [Google Scholar] [CrossRef]
- Peterson, S.W. Phylogenetic analysis of Aspergillus species using DNA sequences from four loci. Mycologia 2008, 100, 205–226. [Google Scholar] [CrossRef]
- Soares, C.; Rodrigues, P.; Peterson, S.W.; Lima, N.; Venâncio, A. Three new species of Aspergillus section Flavi isolated from almonds and maize in Portugal. Mycologia 2012, 104, 682–697. [Google Scholar] [CrossRef] [PubMed]
- Horn, B.W. Colonization of wounded peanut seeds by soil fungi: Selectivity for species from Aspergillus section Flavi. Mycologia 2005, 97, 202–217. [Google Scholar] [CrossRef]
- Hong, S.-B.; Go, S.-J.; Shin, H.-D.; Frisvad, J.C.; Samson, R. a Polyphasic taxonomy of Aspergillus fumigatus and related species. Mycologia 2005, 97, 1316–1329. [Google Scholar] [CrossRef] [PubMed]
- Pitt, J.I.; Hocking, A.D.; Glenn, D.R. An improved medium for the detection of Aspergillus flavus and A. parasiticus. J. Appl. Bacteriol. 1983, 54, 109–114. [Google Scholar] [CrossRef] [PubMed]
- Baggerman, W.I. A modified Rose Bengal medium for the enumeration of yeasts and moulds from foods. Eur. J. Appl. Microbiol. Biotechnol. 1981, 12, 242–247. [Google Scholar] [CrossRef]
- Lin, M.T.; Dianese, J.C. A Coconut-Agar Medium for Rapid Detection of Aflatoxin Production by Aspergillus spp. Phytopathology 1976, 66, 1466–1469. [Google Scholar] [CrossRef]
- Rodrigues, P.; Venâncio, A.; Lima, N. Aflatoxigenic Fungi and Aflatoxins in Portuguese Almonds. Sci. World J. 2012, 2012, 1–9. [Google Scholar] [CrossRef]
- Rodríguez, A.; Rodríguez, M.; Luque, M.I.; Martín, A.; Córdoba, J.J. Real-time PCR assays for detection and quantification of aflatoxin-producing molds in foods. Food Microbiol. 2012, 31, 89–99. [Google Scholar] [CrossRef]
- Cary, J.W.; Klich, M.A.; Beltz, S.B. Characterization of aflatoxin-producing fungi outside of Aspergillus section Flavi. Mycologia 2005, 97, 425–432. [Google Scholar] [CrossRef]
- Richard, E.; Heutte, N.; Bouchart, V.; Garon, D. Evaluation of fungal contamination and mycotoxin production in maize silage. Anim. Feed Sci. Technol. 2009, 148, 309–320. [Google Scholar] [CrossRef]
- Mostafa, A.; Armin, A.; Hamid, P.; Reza, A.M. Rapid Detection Methods for Analysis of Fungi and Mycotoxins in Agriculture Products. Res. J. Recent Sci. 2012, 1, 90–98. [Google Scholar]
- Wacoo, A.P.; Wendiro, D.; Vuzi, P.C.; Hawumba, J.F. Methods for Detection of Aflatoxins in Agricultural Food Crops. J. Appl. Chem. 2014, 2014, 1–15. [Google Scholar] [CrossRef]
- Beley, M.A.J.; Teves, F.G.; Reina, M.; Madamba, S.B. Isolation of Fungal Species and Detection of Aflatoxin from Soy Milk Products using ELISA method. Int. Res. J. Biol. Sci. 2013, 2, 45–48. [Google Scholar]
- Abbas, H.K.; Zablotowicz, R.M.; Weaver, M.A.; Horn, B.W.; Xie, W.; Shier, W.T. Comparison of cultural and analytical methods for determination of aflatoxin production by Mississippi Delta Aspergillu isolates. Can. J. Microbiol. 2004, 50, 193–199. [Google Scholar] [CrossRef] [PubMed]
- Singh, D.; Radhakrishnan, T.; Kumar, V.; Bagwan, N.B.; Basu, M.S.; Dobaria, J.R.; Mishra, G.P.; Chanda, S.V. Molecular characterisation of Aspergillus flavus isolates from peanut fields in India using AFLP. Brazilian J. Microbiol. 2015, 46, 673–682. [Google Scholar] [CrossRef] [PubMed][Green Version]
- Abalunan, A.J.F.; Teves, F.G.; Madamba, M.R.S.B. Isolation of Fungal Species and Aflatoxin Detection in Fermented Products. Int. Res. J. Biol. Sci. 2013, 2, 51–54. [Google Scholar]
- Levin, R.E. PCR detection of aflatoxin producing fungi and its limitations. Int. J. Food Microbiol. 2012, 156, 1–6. [Google Scholar] [CrossRef]
- Luo, J.; Vogel, R.F.; Niessen, L. Rapid detection of aflatoxin producing fungi in food by real-time quantitative loop-mediated isothermal ampli fi cation. Food Microbiol. 2014, 44, 142–148. [Google Scholar] [CrossRef]
- Niessen, L. PCR-based diagnosis and quantification of mycotoxin producing fungi. Int. J. Food Microbiol. 2007, 119, 38–46. [Google Scholar] [CrossRef]
- Yabe, K.; Hatabayashi, H.; Ikehata, A.; Zheng, Y.; Kushiro, M. Development of the dichlorvos-ammonia (DV-AM) method for the visual detection of aflatoxigenic fungi. Appl. Microbiol. Biotechnol. 2015, 99, 10681–10694. [Google Scholar] [CrossRef]
- Yabe, K.; Chihaya, N.; Hamamatsu, S.; Sakuno, E.; Hamasaki, T.; Nakajima, H.; Bennett, J.W. Enzymatic conversion of averufin to hydroxyversicolorone and elucidation of a novel metabolic grid involved in aflatoxin biosynthesis. Appl. Environ. Microbiol. 2003, 69, 66–73. [Google Scholar] [CrossRef] [PubMed]
- Kushiro, M.; Hatabayashi, H.; Zheng, Y.; Yabe, K. Application of newly-developed dichlorvos–ammonia (DV–AM) method to direct isolation of aflatoxigenic fungi from field soils. Mycoscience 2017. [Google Scholar] [CrossRef]
- Kushiro, M.; Hatabayashi, H.; Yabe, K.; Loladze, A. Detection of aflatoxigenic and atoxigenic Mexican Aspergillus strains by the dichlorvos–ammonia (DV–AM) method. Toxins 2018, 10. [Google Scholar] [CrossRef] [PubMed]
- Kushiro, M.; Hatabayashi, H.; Nakagawa, H.; Yabe, K. Isolation of minor aflatoxigenic fungi using dichlorvos-ammonia (DV-AM) method. JSM Mycotoxins 2018, 68, 13–18. [Google Scholar] [CrossRef]
- Yabe, K.; Nakamura, H.; Ando, Y.; Terakado, N.; Nakajima, H.; Hamasaki, T. Isolation and characterization of Aspergillus parasiticus mutants with impaired aflatoxin production by a novel tip culture method. Appl. Environ. Microbiol. 1988, 54, 2096–2100. [Google Scholar] [PubMed]
- Venisetty, R.K.; Keshetty, S.; Ciddi, V. Optimization of surfactant and polymer concentration to alter the morphology of matt forming fungal cultures. Int. J. Pharma. Bio. Sci. 2014, 3, 47–53. [Google Scholar]
- Samson, R.A.; Houbraken, J.; Thrane, U.; Frisvad, J.C.; Andersen, B. Food and indoor fungi. In Food and Indoor Fungi; CBS-KNAW Fungal Biodiversity Centre: Utrecht, The Netherlands, 2010. [Google Scholar]
- Hua, S.-S.T.; Baker, J.L.; Flores-Espiritu, M. Interactions of Saprophytic Yeasts with a nor Mutant of Aspergillus flavus. Appl. Environ. Microbiol. 1999, 65, 2738–2740. [Google Scholar]
- Muñoz, R.; Arena, M.E.; Silva, J.; and González, S.N. Inhibition of mycotoxin-producing Aspergillus nomius VSC 23 by lactic acid bacteria and Saccharomyces cerevisiae. Braz. J. Microbiol. 2010, 41, 1019–1026. [Google Scholar] [CrossRef]
- Komor, E.; Weber, H.; Tanner, W. Greatly decreased susceptibility of nonmetabolizing cells towards detergents. Proc. Natl. Acad. Sci. USA 1979, 76, 1814–1818. [Google Scholar] [CrossRef]
- Massi, F.P.; Penha, R.E.S.; Cavalcante, M.C.; Viaro, H.P.; da Silva, J.J.; de Souza Ferranti, L.; Fungaro, M.H.P. Identification of Aspergillus nomius in Bees Visiting Brazil Nut Flowers. Microbes Environ. 2015, 30, 273–275. [Google Scholar] [CrossRef]
- Horn, B.W.; Greene, R.L.; Sorensen, R.B.; Blankenship, P.D.; Dorner, J.W. Conidial movement of nontoxigenic Aspergillus flavus and A. parasiticus in peanut fields following application to soil. Mycopathologia 2001, 151, 81–92. [Google Scholar] [CrossRef] [PubMed]
- Manabe, M.; Tsuruta, O. Geographical Distribution of Aflatoxin-producing Fungi Inhabiting in Southeast Asia. JARQ 1978, 12, 224–227. [Google Scholar]
- Yabe, K.; Yan, P.S.; Song, Y.; Ichinomiya, M.; Nakagawa, H.; Shima, Y.; Ando, Y.; Sakuno, E.; Nakajima, H. Isolation of microorganisms and substances inhibitory to aflatoxin production. Food Addit. Contam. Part A Chem. Anal. Control. Expo. Risk Assess. 2008, 25, 1111–1117. [Google Scholar] [CrossRef] [PubMed]
- Takahashi, H.; Kamimura, H.; Ichinoe, M. Distribution of aflatoxin-producing Aspergillus flavus and Aspergillus parasiticus in sugarcane fields in the southernmost islands of Japan. J. Food Prot. 2004, 67, 90–95. [Google Scholar] [CrossRef] [PubMed]
- Saito, M.; Okazak, H.; Tanaka, K.; Kushiro, M. Distribution of Aspergillus flavus and A. parasiticus in field soils from Ibaraki and Chiba Prefectures. Rep. Natl. Food Res. Inst. 2008, 72, 77–81. [Google Scholar]
- Takahashi, T. Distribution and characteristics of aflatoxin-producing Aspergillus flavus in the soil in Kanagawa Prefecture, Central Japan. Mycopathologia 1993, 121, 169–173. [Google Scholar] [CrossRef]
- Yabe, K.; Ando, Y.; Hamasaki, T. Biosynthetic Relationship among aflatoxins B1, B2, G1, and G2. Appl. Environ. Microbiol. 1988, 54, 2101–2106. [Google Scholar] [PubMed]
- Turek, B.; Gregarova-Matyasova, J. Occurrence of aflatoxins in food. Ces. Hyg. 1982, 27, 270–274. [Google Scholar]
- Yan, P.; Song, Y.; Sakuno, E.; Nakajima, H. Cyclo (l-Leucyl-l-Prolyl) produced by Achromobacter xylosoxidans inhibits aflatoxin production by Aspergillus parasiticus. Appl. Environ. Microbiol. 2004, 70, 7466–7473. [Google Scholar] [CrossRef] [PubMed]

© 2018 by the authors. Licensee MDPI, Basel, Switzerland. This article is an open access article distributed under the terms and conditions of the Creative Commons Attribution (CC BY) license (http://creativecommons.org/licenses/by/4.0/).
Share and Cite
Yabe, K.; Ozaki, H.; Maruyama, T.; Hayashi, K.; Matto, Y.; Ishizaka, M.; Makita, T.; Noma, S.-y.; Fujiwara, K.; Kushiro, M. Improvement of the Culture Medium for the Dichlorvos-Ammonia (DV-AM) Method to Selectively Detect Aflatoxigenic Fungi in Soil. Toxins 2018, 10, 519. https://doi.org/10.3390/toxins10120519
Yabe K, Ozaki H, Maruyama T, Hayashi K, Matto Y, Ishizaka M, Makita T, Noma S-y, Fujiwara K, Kushiro M. Improvement of the Culture Medium for the Dichlorvos-Ammonia (DV-AM) Method to Selectively Detect Aflatoxigenic Fungi in Soil. Toxins. 2018; 10(12):519. https://doi.org/10.3390/toxins10120519
Chicago/Turabian StyleYabe, Kimiko, Haruna Ozaki, Takuya Maruyama, Keisuke Hayashi, Yuki Matto, Marika Ishizaka, Takeru Makita, Syun-ya Noma, Kousuke Fujiwara, and Masayo Kushiro. 2018. "Improvement of the Culture Medium for the Dichlorvos-Ammonia (DV-AM) Method to Selectively Detect Aflatoxigenic Fungi in Soil" Toxins 10, no. 12: 519. https://doi.org/10.3390/toxins10120519
APA StyleYabe, K., Ozaki, H., Maruyama, T., Hayashi, K., Matto, Y., Ishizaka, M., Makita, T., Noma, S.-y., Fujiwara, K., & Kushiro, M. (2018). Improvement of the Culture Medium for the Dichlorvos-Ammonia (DV-AM) Method to Selectively Detect Aflatoxigenic Fungi in Soil. Toxins, 10(12), 519. https://doi.org/10.3390/toxins10120519

